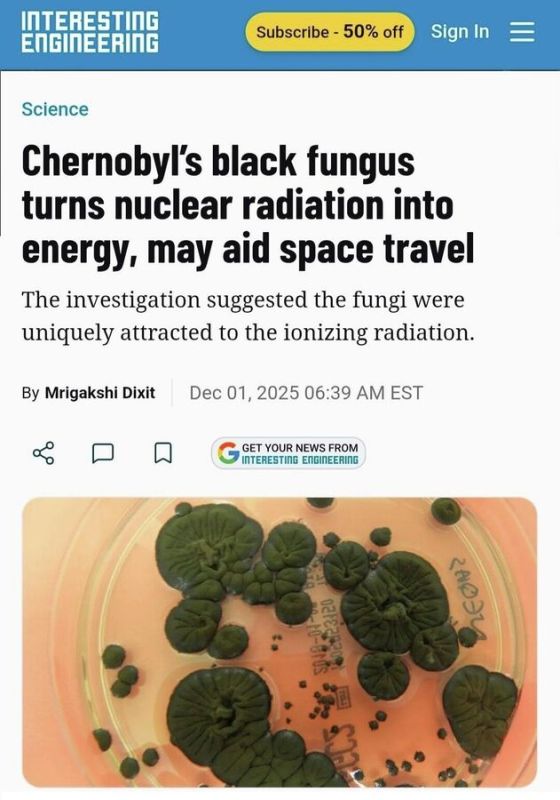
На территории Чернобыльской зоны отчуждения обнаружили уникальный грибок, который питается сильной радиацией и превращает ее в энергию

На территории Чернобыльской зоны отчуждения обнаружили уникальный грибок, который питается сильной радиацией и превращает ее в энергию
На территории Чернобыльской зоны отчуждения обнаружили уникальный грибок, который питается сильной радиацией и превращает ее в энергию.
Открытие может кардинально изменить подходы к защите и строительству станций и колоний в космосе, сообщает научное издание Іnteresting engineering.
Cladosporium sphaerospermum показал на МКС рост на 20% быстрее, чем на Земле. Из него можно сделать биологический щит, который станет лёгкой и дешёвой альтернативой привычной защите.
Спутник Ближнее зарубежье в MAX